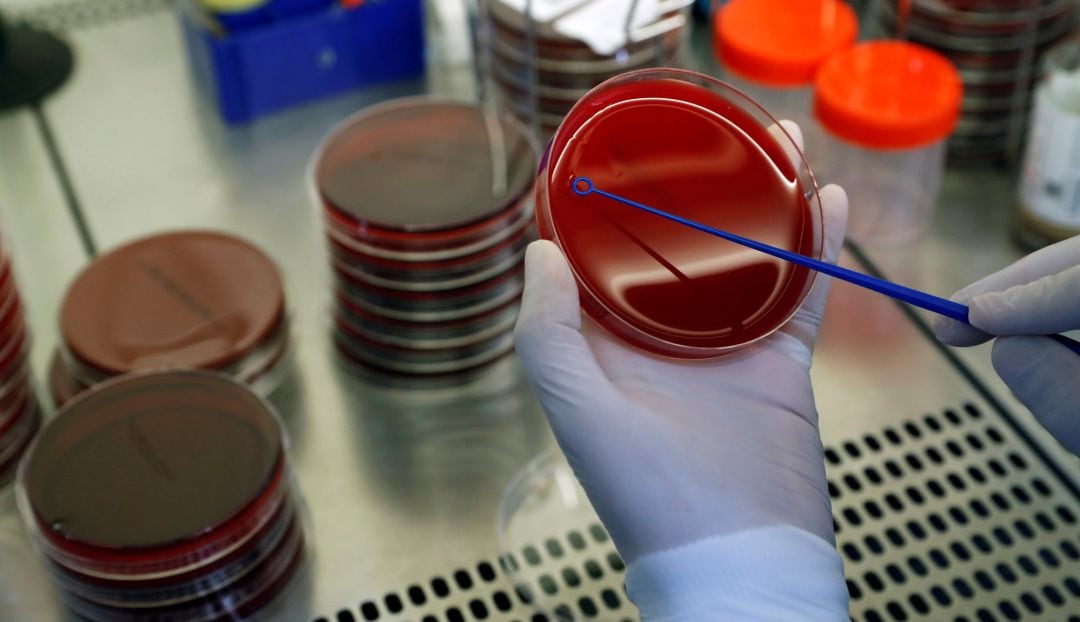
Imatge d'arxiu d'un laboratori

La Universitat de Barcelona investiga la mort d'un científic que estudiava una malaltia contagiosa letal
Guardava mostres no autoritzades de Creutzfeldt-Jakob al congelador del seu laboratori, a la Universitat de Barcelona

Imatge d'arxiu d'un laboratori / MURAD SEZER (Reuters)
Barcelona
La Universitat de Barcelona va obrir fa tres mesos una investigació interna per aclarir les causes de la mort d'un científic que estudiava la malaltia neurodegenerativa de Creutzfeldt-Jakob i que tenia al congelador del seu laboratori milers de mostres no autoritzades, segons explica El País. L'home, de 45 anys, va morir l'any passat amb símptomes compatibles amb aquesta patologia semblant a la de les vaques boges. Treballava com a bioquímic al centre IDIBELL, que també s'ha sumat a la investigació, juntament amb el consorci públic CIBER.
El científic va començar a trobar-se malament el novembre del 2020 i va demanar la baixa. Un mes després, de manera fortuïta, es van descobrir mostres sospitoses de líquid cefalorraquidi de persones amb la malaltia de Creutzfeldt-Jakob i altres demències neurodegeneratives, segons la documentació a què ha tingut accés El País. Cap no tenia registre d'entrada al seu laboratori de la Facultat de Medicina, a l'Hospitalet de Llobregat, que no estava preparat per tractar aquests elements d'alt risc biològic. Segons les fonts del rotatiu, s'haurien d'haver portat a les instal·lacions de Bellaterra, però calia esperar torn per poder desar aquest material.
Proves mèdiques i suport psicològic
La Universitat va tancar i descontaminar el laboratori immediatament. Segons un comunicat de l'IDIBELL, les mostres van ser enviades a unes instal·lacions de màxima seguretat i fins al març del 2023 no es va confirmar que eren infeccioses. Al mateix comunicat, asseguren que el centre va oferir a la resta d'usuaris del laboratori de la UB la realització de proves mèdiques i suport psicològic. De fet, destaca El País que hi ha molta preocupació entre els professionals que compartien aquesta instal·lació perquè no saben a quin nivell de risc han estat exposats i els queda el dubte de si, d'aquí a uns anys, podrien arribar a presentar símptomes com una ràpida demència o la rigidesa muscular. Aquesta malaltia neurodegenerativa s'incuba en silenci durant un temps, però l'esperança de vida després del diagnòstic és de sis mesos.





